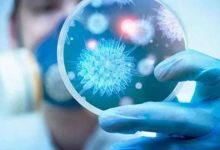

-
اهم الأخبار
عوامل تساعد على خروج حصوات الكلى بشكل طبيعي دون جراحة
تُعد حصوات الكلى من المشكلات الصحية المزعجة والمؤلمة، خاصة عندما تكون كبيرة الحجم، إذ قد تسبب نوبات ألم حادة تستمر من دقائق إلى ساعات، بحسب حجم الحصوة وموقعها. أما الحصوات الصغيرة (أقل من 6 مم)،…
-
-
-
-
-
أمومة وطفولة
مخاوف صحية متزايدة.. سماعات الموبايل عادة يومية تتحول إلى ظاهرة بين الشباب والأطفال
لم تعد سماعات الموبايل مجرد وسيلة للاستماع إلى الموسيقى أو إجراء المكالمات، بل تحولت في السنوات الأخيرة إلى جزء أساسي من الحياة اليومية، خاصة بين الشباب والفتيات، بل وامتد استخدامها ليشمل الأطفال أيضًا، في ظاهرة…
-
-
-
-